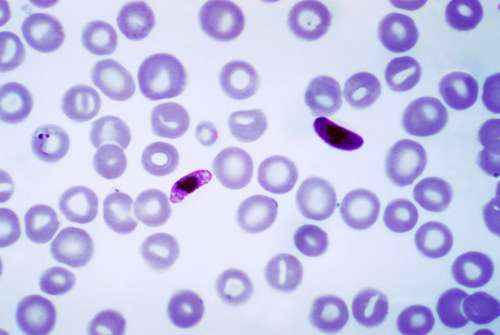

Патогены: основные типы и способы передачи возбудителей инфекции
Патогены представляют собой микроскопические организмы, которые вызывают или могут вызывать заболевание. Различные виды возбудителей инфекций включают бактерии, вирусы, протисты (амеба, плазмодий и т. д.), грибы, паразитические черви (плоские черви и круглые черви ) и прионы. Хотя эти патогены вызывают множество заболеваний, начиная от незначительных до опасных для жизни, важно отметить, что не все бактерии являются патогенными.
Фактически, наш организм содержит тысячи видов бактерий, грибов и простейших, которые являются неотъемлемой частью микробиома (микрофлоры) человека. Эти микроорганизмы полезны и важны для правильной работы биологических процессов, таких как пищеварение и функция иммунной системы. Они вызывают проблемы только в редких случаях, когда ослабевают функции иммунной системы. Напротив, действительно патогенные организмы имеют одну цель: выжить и размножаться любой ценой. Возбудители инфекций специально приспособлены для заражения живых организмов в обход иммунной системы хозяина. Они распространяются внутри тела и покидают его для заражения другого хозяина.
Как передаются патогены?
Патогены могут передаваться либо прямым, либо косвенным путем. Прямая передача включает распространение патогенов путем прямого контакта тела с телом. Такой тип передачи может происходить от матери к ребенку, как показано на примере ВИЧ, вируса Зика и сифилиса. Другие типы прямого контакта, через которые могут распространяться патогены, включают касание (метициллин-резистентный стафилококк), поцелуи (простой герпес) и сексуальный контакт (папилломавирусы человека).
Патогены способны также распространяться путем косвенной передачи, которая включает контакт с поверхностью или веществом, которые заражены вредоносными микроорганизмами, а также контакт и передача через животное или укс насекомых. Типы косвенной передачи включают:
- Воздушно-капельный (как правило, чиханьем, кашлем, смехом и т. д.). Вредоносные микроорганизмы остаются подвешенным в воздухе и вдыхается или контактирует с дыхательными мембранами другого человека.
- Капельки — патогены, содержащиеся в каплях жидкости организма (слюна, кровь и т. д.) контактируют с другим человеком или загрязняют поверхность. Капли слюны чаще всего распространяются через чиханье или кашель.
- Еда — передача инфекции происходит путем употребления зараженной и неправильно обработанной пищи.
- Вода — патоген распространяется через потребление или контакт с загрязненной водой.
- Животные — патоген распространяется от животных к людям. К примеру, при укусе насекомых или контакте людей с дикими или домашними животни.
Несмотря на то, что невозможно полностью предотвратить передачу патогенов, лучший способ минимизировать вероятность инфекционных заболеванием — поддерживать правильную гигиену. Не забывайте мыть руки после использования туалета, обрабатывайте сырые продукты и различные поверхности, которые подвергаются воздействию микробов, а также своевременно убирайте экскременты домашних питомцев.
Типы патогенов
Патогены очень разнообразны и состоят из прокариотических и эукариотических организмов. Наиболее распространенными патогенами являются бактерии и вирусы. Хотя оба способны вызвать инфекционное заболевание, бактерии и вирусы отличаются друг от друга. Бактерии являются прокариотическими клетками, которые вызывают заболевание, продуцируя токсины. Вирусы представляют собой частицы нуклеиновой кислоты (ДНК или РНК), заключенные внутри оболочки белка или капсида. Они вызывают заболевание, захватывая клеточную систему своего хозяина, чтобы создать многочисленные копии вируса. Эта активность уничтожает клетку-хозяина в процессе. Эукариотические возбудители инфекций включают грибы, протистов и паразитических червей.
Прионы — это уникальный тип патогена, который является белком, а не живым организмом. Белки прионов имеют те же аминокислотные последовательности, что и обычные белки, но сложены в неправильную форму. Эта измененная форма делает прионные белки заразными, поскольку они влияют на другие нормальные белки, заставляя спонтанно принимать инфекционную форму. Прионы обычно влияют на центральную нервную систему. Они, как правило, собираются вместе в тканях мозга, что приводит к ухудшению состояния мозга. Прионы вызывают смертельное нейродегенеративное заболевание Крейтцфельдта-Якоба у людей, а также губчатую энцефалопатию у крупного рогатого скота.
Бактерии
Бактерии ответственны за ряд инфекций, которые варьируются от бессимптомных до внезапных и интенсивных. Заболевания, вызванные патогенными бактериями, обычно являются результатом производства токсинов. Эндотоксины служат компонентами стенки бактериальных клеток, высвобождающиеся после смерти или ухудшения состояния бактерий. Эти токсины вызывают различные симптомы, включая лихорадку, изменения артериального давления, озноб, септический шок, повреждение органов и даже смерть.
Экзотоксины продуцируются бактериями и высвобождаются в окружающую среду. Три типа экзотоксинов включают цитотоксины, нейротоксины и энтеротоксины. Цитотоксины повреждают или уничтожают определенные типы клеток организма. Бактерии Streptococcus pyogenes продуцируют цитотоксины, называемые эритротоксинами, которые разрушают клетки крови, повреждают капилляры и вызывают симптомы, связанные с некротическим фасциитом.
Нейротоксины являются ядовитыми веществами, которые действуют на нервную систему и мозг. Бактерии Clostridium botulinum высвобождают нейротоксин, вызывающий мышечный паралич. Энтеротоксины влияют на клетки кишечника, провоцируя сильную рвоту и диарею. Бактериальные виды, которые производят энтеротоксины, включают Bacillus, Clostridium, Escherichia, Staphylococcus и Vibrio.
Примеры патогенных бактерий и вызываемых ими заболеваний
- Clostridium botulinum: отравление ботулизмом, затрудненное дыхание, паралич;
- Streptococcus pneumoniae: пневмония, ангина, менингит;
-
Mycobacterium tuberculosis: туберкулез;
- Escherichia coli O157:H7: геморрагический колит;
- Staphylococcus aureus (включая MRSA ): воспаление кожи, инфекция крови, менингит;
- Vibrio cholerae: холера.
Вирусы
Вирусы — это уникальные патогены, поскольку они не являются клетками, а сегментами ДНК или РНК, заключенными внутри капсида (белковая оболочка). Они вызывают заболевание, заражая клетки и заставляя клеточные структуры вырабатывать больше вирусов быстрыми темпами. Вирусы противодействуют или предотвращают обнаружение иммунной системой и энергично размножают внутри клетки-хозяина. Эти микроскопические вредоносные частички инфицируют не только клетки животных и растений, но также заражают бактерии и археи.
Вирусные инфекции у людей варьируются по тяжести от умеренных до смертельно опасных (Эбола). Они часто мигрируют и заражают определенные ткани или органы в организме. Вирус гриппа имеет родство с тканям дыхательной системы, что приводит к симптомам, затрудняющим дыхание. Вирус бешенства обычно заражает ткани центральной нервной системы, а различные вирусы гепатита локализируются в печени. Некоторые вирусы также связаны с развитием определенных типов рака. Вирусы папилломы человека связаны с раком шейки матки, гепатит В и С провоцируют возникновения рака печени, а вирус Эпштейна-Барра связан с лимфомой Беркитта.
Примеры вирусов и вызываемых ими заболеваний
- Вирус Эбола: геморрагическая лихорадка Эбола;
- Вирус иммунодефицита человека (ВИЧ): пневмония, фарингит, менингит;
- Вирус гриппа: грипп, вирусная пневмония;
- Норовирус: вирусный гастроэнтерит (желудочный грипп);
- Вирус ветряной оспы: ветряная оспа (ветрянка);
- Вирус Зика: вирусная болезнь Зика, микроцефалия (у младенцев).
Грибы
Грибы — эукариотические организмы, которые включают дрожжи и плесень. Заболевание, вызванное грибами, редко встречается у людей и обычно является результатом повреждения физического барьера (кожи, слизистой оболочки и т.д.) или нарушений в работе иммунной системы. Патогенные грибы часто вызывают заболевание, переходя от одной формы роста к другой. То есть, одноклеточные дрожжи демонстрируют обратимый рост от дрожжеподобной до плесневой формы, тогда как плесень переходит к дрожжеподобному росту.
Дрожжи Candida albicans меняют морфологию, переключаясь с округлого возрастающего роста клеток на плетевидный (нитевидный) удлиненный клеточный рост, основанный на ряде факторов. Эти факторы включают изменения температуры тела, рН и наличия определенных гормонов. C. albicans вызывает вагинальные дрожжевые инфекции. Подобным же образом гриб Histoplasma capsulatum существует как нитчатая плесень в естественной среде обитания почвы, но при попадании в организм переключается на почкообразный рост дрожжей. Импульсом для этого изменения является повышенная температура в легких по сравнению с температурой почвы. H. capsulatum вызывает тип инфекции легких, называемый гистоплазмозом, который может развиться в легочные заболевания.
Примеры патогенных грибов и вызываемых ими заболеваний
- Aspergillus spp.: бронхиальная астма, аспергиллез легких;
- Candida albicans: оральный кандидоз, вагинальные дрожжевые инфекции;
- Epidermophyton spp.: атлетическая стопа, стригущий лишай;
- Histoplasma capsulatum: гистоплазмоз, пневмония;
- Trichophyton spp.: заболевания кожи, волос и ногтей.
Простейшие
Простейшие — крошечные одноклеточные организмы из царства протисты. Это очень разнообразное царство включает в себя такие организмы, как водоросли, амебы, эвглена, плазмодий и слизевики. Большинство протистов, которые вызывают заболевание у людей, являются простейшими. Они делают это путем паразитного питания и размножения за счет хозяина. Паразитарные простейшие обычно передаются людям через зараженную почву, пищу или воду. Они также могут передаваться животными и через укусы насекомых.
Амеба Naegleria fowleri, обычно встречающаяся в почвенных и пресноводных местах обитания, также называется мозговой амебой, так как вызывает заболевание, называемое первичным амебным менингоэнцефалитом (ПАМ). Эта редкая инфекция обычно возникает, когда люди купаются в зараженной воде. Амеба мигрирует из носа в мозг, где повреждает ткани мозга.
Примеры патогенных простейших и вызываемых ими заболеваний
- Giardia lamblia: лямблиоз (диарейные заболевания);
- Entamoeba histolytica: амебная дизентерия, амебный абсцесс печени;
- Plasmodium spp.: малярия;
- Trypanosoma brucei: африканская сонная болезнь;
- Trichomonas vaginalis: трихомониаз (инфекция, передающаяся половым путем);
- Toxoplasma gondii: токсоплазмоз, биполярное расстройство, депрессия, болезни глаз.
Паразитические черви
Эти паразиты заражают ряд различных организмов, включая растения, насекомых и животных. Паразитические черви, также называемые гельминтами, включают нематоды (круглые черви) и платигельминт (плоские черви). Анкилостомы, острицы, нитевидные черви, власоглав и трихинеллы являются типами паразитических круглых червей. Паразитические плоские черви включают ленточных червей и трематод. У людей большинство этих червей заражают кишечник, но иногда распространяются на другие участки тела. Кишечные паразиты прикрепляются к стенкам пищеварительного тракта и питаются за счет хозяина. Они производят тысячи яиц, которые вылупляются либо внутри, либо снаружи тела.
Паразитические черви распространяются через контакт с загрязненной пищей и водой. Они также могут передаваться от животных и насекомых людям. Не все паразитические черви заражают пищеварительный тракт. Плоские черви — шистосомы могут проникать в органы тела (печень, селезенка, легкие), вызывая потерю крови, обструкцию толстой кишки, увеличение селезенки или чрезмерное накопление жидкости в брюшной полости. После того, как самки откладывают яйца, некоторое количество яиц выходит из организма с мочой или фекалиями. Шистосомы передаются при контакте с зараженной личинками водой. Они попадают в организм, проникая через кожу.
Примеры паразитических червей и вызываемых ими заболеваний
- Человеческая аскарида (Ascaris lumbricoides): аскаридоз (астма-подобные симптомы, желудочно-кишечные осложнения);
- Echinococcus spp.: кистозный эхинококкоз (развитие кисты), альвеолярный эхинококкоз (болезнь легких);
- Schistosoma mansoni: шистосомоз (кровавый стул или моча, желудочно-кишечные осложнения, повреждение органов);
- Угрица кишечная (Strongyloides stercoralis): сильное злокачественное заболевание (кожная сыпь, желудочно-кишечные осложнения, паразитарная пневмония);
- Свиной цепень (Taenia solium): желудочно-кишечные осложнения, цистицеркоз;
- Трихинелла спиралис (Trichinella spiralis): трихинеллез (отек, менингит, энцефалит, миокардит, пневмония).